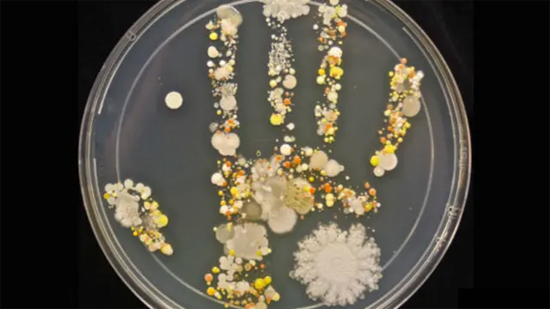
Microscopic view of bacteria and viruses invisible to the naked eye

If you cannot see something, that does not mean it does not exist, does it? I can give a few simple examples, like radio waves, or the Wi-Fi you are probably using right now, or the colors that fall outside the spectrum between infrared and ultraviolet because our eyes only have receptors sensitive to a specific range of light wavelengths. Some animals can actually see these other “colors.” Another example is all the microorganisms constantly moving around us, like viruses and bacteria.
Of course, with the right instruments we can detect, measure, study, and even “see” what cannot be perceived by the naked eye. We do not see Wi-Fi, but there are many ways to know it is there, such as the fact that we are connected to the internet. There are specific instruments that detect infrared and ultraviolet light, such as sensors, thermal cameras, UV-sensitive papers, and more. A simple microscope is enough to see microorganisms.
And what about all the things that we not only cannot see, but also cannot detect by any other means? Can we really conclude that something does not exist simply because we cannot see or detect it? For example, thoughts. You can see a person, feel their warmth, notice their scent, but you cannot see or “read” their thoughts. Yet you know they exist — just as your own do.
Many people claim to have seen UFOs, ghosts, legendary creatures, and even aliens. Such an experience can radically change someone’s life and the way they perceive the world. They will probably not be able to prove these things, just as we cannot prove what we are thinking or feeling.
If you are the kind of person who needs to see to believe, your world and your reality will be very limited. At the same time, you should not believe everything simply because you read it or someone told you about it. Wouldn’t it be more interesting to think in terms of possibilities instead of merely believing or not believing in things?
There are many things around us that are part of our lives, and the fact that they are invisible does not necessarily mean they do not exist. Think in possibilities, use logic, reason, and intuition, study, seek knowledge, and filter what is useful for you.
When your intuition, your faith, and your logic point in the same direction, you will not need to see in order to be certain that something exists.

Bees, some birds, and reptiles can see in the ultraviolet spectrum. Among birds, this ability may help them recognize individuals with more attractive plumage for mating, or even make it easier to spot their prey.
Surgeries without handwashing
In the past, doctors did not wash their hands before surgeries, nor did they use gloves—something that feels almost unthinkable today. At that time, the importance of hygiene in preventing disease was not yet understood, and many procedures were carried out without any concern for contamination. It was only in the 19th century that this began to change, when medical research revealed the connection between cleanliness, infections, and mortality. From then on, aseptic practices were gradually adopted, forever transforming the safety of surgeries and saving countless lives.

“God is the invisible made evident”
Victor Hugo
Enjoyed this? Keep reading the other articles. The topics are related, but they do not follow a specific order.
Share this article:
Enjoyed this? Keep reading the other articles. The topics are related, but they do not follow a specific order.
Share this article:


